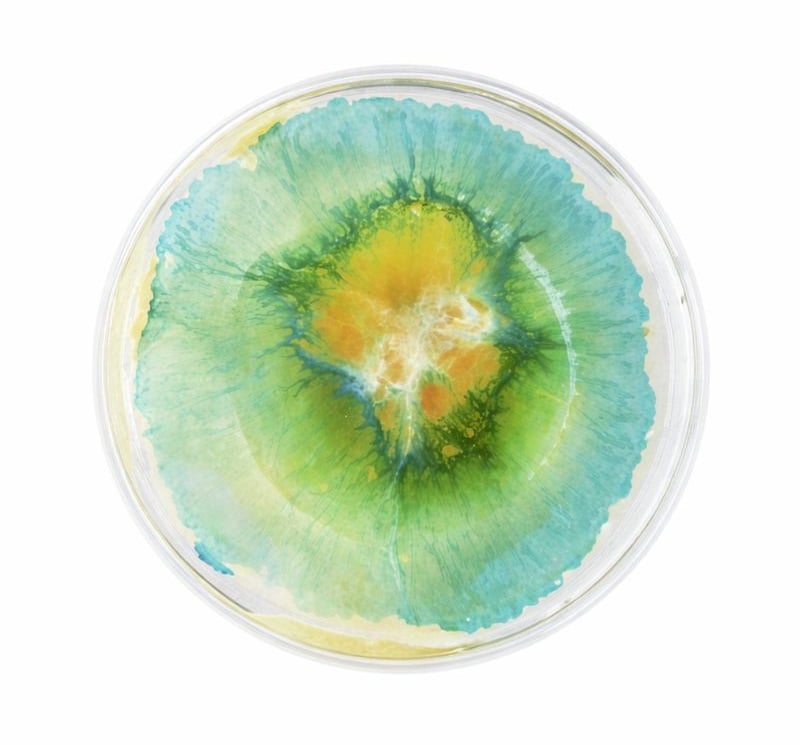
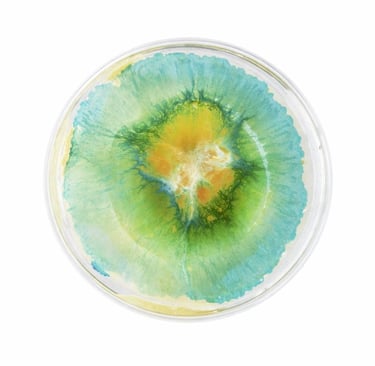

Veppa Services
Controlled environmental cleaning & care
for spaces where materials, exposure, and
outcomes must be managed — not
guessed.
Informed by applied chemistry, systems thinking, and
real-world operational experience.
Veppa’s methodology is shaped by extensive field experience with professional chemical systems, hospitality environments, and applied environmental-health frameworks. This background informs how environments are evaluated, how interventions are selected, and how outcomes are managed over time.
TWO EXPRESSIONS,
ONE STANDARD



Commercial Care
Environmental care for facilities where exposure, traffic, and operational demands require structured systems.
Residential Care
Tailored, material-aware care designed to preserve surfaces, finishes, and long-term integrity.


How Veppa Works
Veppa approaches environments through structured assessment, tailored protocol design, controlled application, and ongoing consistency.
Rather than applying uniform procedures, each space is evaluated based on materials, usage patterns, and environmental conditions to support long-term stability and surface integrity.


Begin with Understanding
Every engagement starts with a structured assessment of your environment, materials, and conditions.